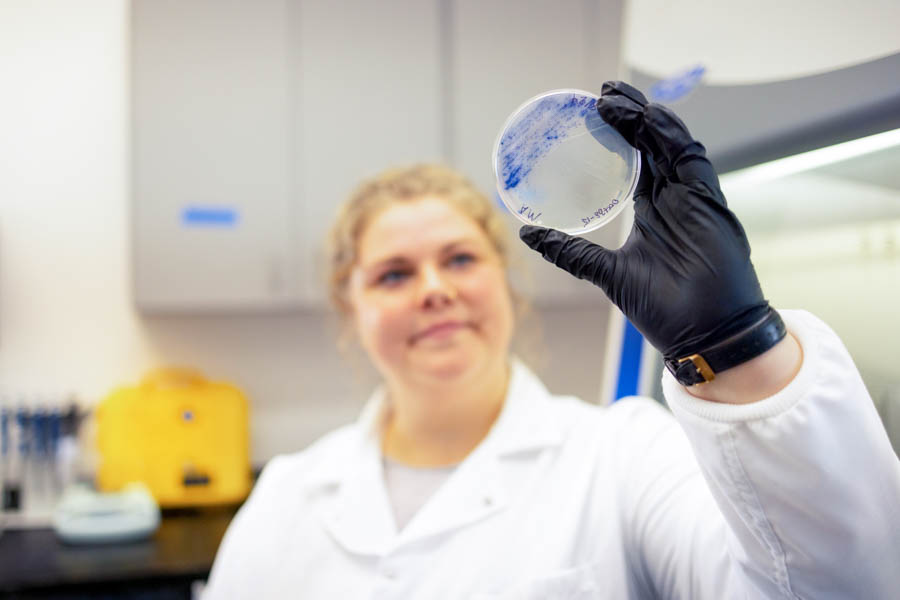

Dr. Francis was born and raised in Florida and has heard the call of the ocean her whole life. She holds a B.S. in Marine Science and Microbiology Immunology from the Rosenstiel School of Marine, Atmospheric and Earth Science at the University of Miami, an M.S. in Biology from Florida Atlantic University and a Ph.D. in Integrative Biology from the Harbor Branch Oceanographic Institute at Florida Atlantic University. During her studies at Harbor Branch Oceanographic Institute, Francis was mentored by award-winning chemist Dr. Amy Wright, who inspired her to research secondary metabolites, or natural products produced by organisms to perform a certain function. Francis joined Mote last year as part of a philanthropy-funded position that grants her three years to develop a new research program to explore the potential role of natural products produced by marine microorganisms in new drug discovery. She spends her days in the field doing sampling, including a recent trip to Puerto Rico to study the natural products produced by sponges’ microbiomes, and working in the lab on a variety of tasks like DNA extractions, bacterial and fungal culture and chemical extractions and analysis. Most of her research deals with antibiotic drug discovery, but she is also assisting in research for anti-cancer responses.
“The ocean, and specifically marine microorganisms, are a great place to look for medicines because they have evolved to have really interesting chemistry. We call these compounds secondary metabolites, or “natural products” in the context of medicine. Basically, they are chemicals that are produced by organisms that have a function that is not critical for the organisms' survival but provide some type of evolutionary advantage,” Francis says. “What’s really interesting is that a lot of the biochemistry in these organisms is conserved in humans as well, so if something is active in and being produced by these organisms, there’s a chance that it might be active in our human bodies too.” While it may sound complicated, Francis likes to remind people that humans have been discovering natural product medicines throughout our history. “In more recent history, you can think of penicillin which was discovered from a fungus, or morphine from poppy plants. There are marine examples as well, like the anti-cancer drugs Halaven®, which was discovered from a sea sponge, and Yondelis®, which was discovered from a tunicate (sea squirt),” she says. “Now we have the technology to identify what compound is responsible for an activity. That’s a change, but humanity has been doing this for a long time, and there’s a lot of historical knowledge that we can explore.”
Francis explains that these natural products can be found anywhere there is life, but that “the more biodiverse the environment, the higher chance there is that there will have been that evolutionary pressure to evolve a useful secondary metabolite, aka natural product.” Many researchers have studied coral reefs, deep-sea vents and even mangroves, found here in Sarasota, to search for natural products. “A lot of people, especially if they don’t live on the coast or don’t have any connection—they think—to the ocean, they’re not really motivated by (the idea that) this environment is being destroyed, the corals are bleaching and we’re losing these ecosystems,” she adds. “But, if you tell them that we’re getting anti-cancer drugs and new antibiotics and antivirals, all these cool things from these environments, then it might connect with them a little bit more and be a reason why they’ll be motivated to conserve these awesome environments.”